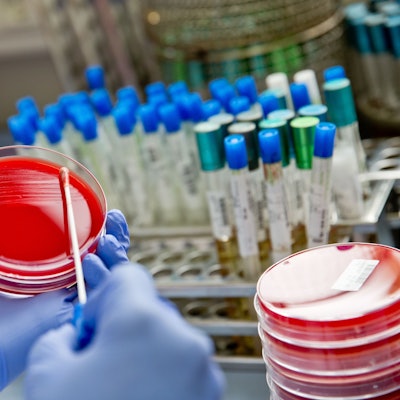
Eine Labormitarbeiterin verstreicht im Diagnostiklabor Untersuchungsmaterial mit einem Abstrichtupfer auf einer Bakterienkulturplatte.

Aus der BZgA wurde das BIÖG. Leiter Dr. Johannes Nießen erklärt, wie sein Team Deutschland gesünder machen will und ob Köln eine Stadt ist, die der Gesundheit guttut.
Bundesinstitut für Öffentliche GesundheitVon Köln aus die Aufklärung einer Nation vorantreiben

Dr. Johannes Nießen leitete bis 2024 das Kölner Gesundheitsamt. Nun ist er Chef des neuen BIÖG, mit dessen Errichtung er 2023 beauftragt wurde.
Copyright: Nabil Hanano
Warum musste die BZgA weiterentwickelt werden?
Über 57 Jahre lang hat die Bundeszentrale für gesundheitliche Aufklärung Köln zu einem Zentrum der Gesundheitskommunikation für ganz Deutschland gemacht und vieles auf den Weg gebracht. Die Kampagne „Gib AIDS keine Chance“ kennt fast jeder. Aber auch „Kenn dein Limit“, wenn es um Alkohol geht, oder „Deutschland sucht den Impfpass“. Die Herausforderungen im Gesundheitssystem sind in den letzten Jahren allerdings deutlich komplexer geworden, nehmen wir die Corona-Pandemie, den Klimawandel oder auch die psychische Gesundheit. Wenn man so vieles angehen will, ist irgendwann der Zeitpunkt erreicht, dass man sich strategisch neu ausrichten muss.
Was macht das Bundesinstitut für Öffentliche Gesundheit (BIÖG) anders als die BZgA?
Die Erfahrungen der Pandemie haben gezeigt, dass die Akteure im Öffentlichen Gesundheitsdienst besser zusammenarbeiten müssen. Es gibt deutschlandweit 378 Gesundheitsämter und jedes hat für sich gearbeitet. Während der Pandemie konnte man zum Beispiel in einem Vorort von Hamburg einen einfachen Mund-Nasen-Schutz tragen und wenn man mit der S-Bahn nach Hamburg reingefahren ist, musste es eine FFP2-Maske sein. Da wollen wir in Zukunft zusammen mit den Ländern den ÖGD bei einer besseren Vernetzung unterstützen.
Auch die enge Zusammenarbeit mit dem Robert-Koch-Institut (RKI) ist neu.
Das RKI generiert zukünftig auch Daten für uns, unter anderem mit der regelmäßigen bundesweiten Befragung „Gesundheit in Deutschland“. Gerade im Bereich der Forschung wird es also einen engen Austausch geben. Wissenschaftliche Erkenntnisse können zukünftig schneller ermittelt und dementsprechend Aktivitäten und Kampagnen des Bundesinstituts für Öffentliche Gesundheit auf den Weg gebracht werden.
Warum braucht die Gesellschaft das BIÖG?
In Deutschland leben die Menschen kürzer als in anderen westeuropäischen Ländern, obwohl wir eines der besten Gesundheitssysteme haben. Wir wollen herausfinden, woran das liegt und gegensteuern. Vor allem müssen wir die Prävention stärken, um hier voranzukommen. Unsere Aufgabe ist es, Menschen zu einem gesunden Lebensstil zu befähigen. Bezogen auf nicht übertragbare Krankheiten wie Herz-Kreislauf-Erkrankungen, Krebs oder Demenz gibt es bereits bewährte Präventionsempfehlungen. Leider erreichen sie nicht immer die Menschen, die es besonders betrifft und für die diese Empfehlungen enorm wichtig wären. Wenn ich aufhören möchte zu rauchen, dann weiß ich, dass es unsere Website www.rauchfrei-info.de gibt. Aber viele wissen das nicht. Das müssen wir ändern.

Aus der BZgA wurde das BIÖG. Der Standort in Ehrenfeld bleibt gleich.
Copyright: Nabil Hanano
Welche konkreten Probleme wollen Sie als Erstes in Angriff nehmen?
Ein großes Thema ist der Klimawandel mit seinen gesundheitlichen Folgen. Ein weiteres wichtiges Thema ist die psychische Gesundheit von Jugendlichen – zu dem Schwerpunkt haben wir vor kurzem noch eine Tagung in Berlin organisiert. Jeder vierte Jugendliche in Deutschland ist inzwischen psychisch belastet – das war vor Corona nicht so. Dass Kinder und Jugendliche gesund aufwachsen können, liegt mir sehr am Herzen. Wenn Eltern das allein nicht schaffen, können wir sie unterstützen und zeigen, wo sie Hilfe bekommen.
Inwiefern ist die Legalisierung von Cannabis ein Thema für das Bundesinstitut für Öffentliche Gesundheit?
Wir erheben seit 1973 regelmäßig eigene Zahlen zur Drogenaffinität von Jugendlichen und wissen daher, dass der Konsum vor allem unter jungen Erwachsenen schon lange Realität ist. Daher klären wir sachlich über die Risiken des Konsums auf, etwa mit der neuen Kampagne „Young, wild & informed“ für junge Konsumierende. Für Fachkräfte gibt es Unterstützung für die Präventionsarbeit auf der Webseite www.infos-cannabis.de.
Wie beurteilen Sie die Legalisierung?
Als Arzt habe ich natürlich Bedenken. Ich weiß, dass das Gehirn erst mit 25 ausgewachsen ist. Wer vorher Cannabis konsumiert, muss mit Gehirnveränderungen rechnen, die geistige Leistungsfähigkeit kann abnehmen, das Risiko für Schizophrenie wird höher. Und wichtig ist, dass junge Leute wissen: Wer regelmäßig Cannabis konsumiert, kann abhängig werden. Ich denke aber, dass die Entkriminalisierung grundsätzlich positiv ist.
Sie haben davon gesprochen, dass die gesundheitlichen Herausforderungen zugenommen haben. War es also früher einfacher, gesund zu bleiben?
Ja, in manchen Bereichen schon. Klimawandel war damals vielen noch ein Fremdwort. Heute erleben wir heiße Sommer mit erheblichen gesundheitlichen Folgen. Wir haben deshalb unseren Hitzeführer an alle Bürgermeister Deutschlands verschickt. Der erklärt, dass es bei Hitze nicht reicht, dass Menschen viel trinken. Es braucht Schatten, kühlende Orte und eine städtische Infrastruktur, die auf Hitze angepasst ist. Entstanden ist dieser Führer durch einen modellhaften Hitzeaktionsplan der Stadt Köln. Dafür hat die Stadt Befragungen durchgeführt und gemerkt, wie unterschiedlich die Verhaltensoptionen der Menschen bei Hitze in Köln sind. In einem Hochhaus bekomme ich die Temperaturen schwerer runter als in einem Einfamilienhaus. Das sind unterschiedliche soziale Voraussetzungen. Der Plan gibt viele Tipps, was die Menschen tun können. Wir haben das für die Republik als Leitfaden übernommen.
Um Gesundheit zu fördern, braucht es also nicht nur aufgeklärte Individuen, sondern auch Investitionen in ihre Umgebung?
Genau, es geht um eine Kombination von Verhaltensprävention und Verhältnisprävention. Ein Beispiel: Man kann Menschen raten, viel Wasser zu trinken. Das hilft aber allein nicht, wenn Krankenhäuser und Seniorenheime überhitzte Räume haben. Es geht dem Bundesinstitut für Öffentliche Gesundheit darum, beides zu tun: Verhaltenstipps geben und gleichzeitig Bedingungen zu schaffen, die es trotz Hitze möglich machen, gut weiterzuleben.
Inwiefern will das BIÖG etwas dafür tun, dass sich die Lage in sozial schwächeren Gegenden verbessert?
Bestes Beispiel ist Chorweiler: Während der Pandemie haben wir dort Tests und Impfungen angeboten und tausende Leute erreicht. Das heißt: Man muss dorthin gehen, wo es brennt und Unterstützung bieten. Das machen wir gemeinsam mit dem Bundesfamilienministerium auch mit dem Programm „Frühe Hilfen“, das Mütter und Kinder in sozial schwierigen Verhältnissen aufsucht - nicht nur in Köln, sondern bundesweit. Solche Netzwerke wollen wir auch für alle anderen Bereiche der Prävention ausbauen, zum Beispiel für ältere Menschen.
Wie wichtig ist es für die Gesundheit der Menschen, in den öffentlichen Raum zu investieren?
Sehr wichtig. Das Bundesinstitut für Öffentliche Gesundheit sieht Gesundheit als Querschnittsthema. Gesundheit hängt stark von unserer Umgebung ab. Parks und Spielplätze fördern Bewegung, gute Radwege machen das Fahrradfahren sicherer. Wir bieten dafür eine Reihe von Instrumenten für verschiedene Altersgruppen. Zum Beispiel haben wir den StadtRaumMonitor entwickelt, ein Online-Instrument, mit dem Menschen ihre Umgebung bewerten können. Die Kommunen können ihn auch nutzen, um Bürgerinnen und Bürger an der Stadtplanung zu beteiligen.
Ist Köln eine Stadt, die die Gesundheit fördert?
Insgesamt ist die Stadt Köln da auf einem guten Weg. Als Leiter des Gesundheitsamtes in Köln durfte ich ja viereinhalb Jahre entsprechende Empfehlungen aussprechen. Wir haben auch viele Studien gemacht, unter anderem zu Gesundheitsangeboten für Kinder. Es gibt immer noch einiges, was man in diesem Bereich besser machen kann. Die Fläche ist begrenzt, was Bewegungsmöglichkeiten angeht. Aber im Bereich der Fahrradwege hat sich in den vergangenen Jahren viel getan und der Grüngürtel bietet tolle Bewegungsmöglichkeiten, die mich immer wieder beeindrucken.